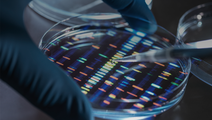
ReachMD Healthcare Image
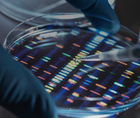
ReachMD Healthcare Image

DDW Action Center
Welcome to the DDW Action Center, bringing you the latest updates from the 2024 Digestive Disease Week (DDW) annual meeting. This collection features expert insights and clinical trial data from the conference that’s dedicated to professionals working in gastroenterology, hepatology, GI endoscopy, gastrointestinal surgery, and other related fields.
Crohn’s Disease Care: Diving into the GEM Integrative Risk Score
DDW Action CenterCrohn’s Disease Care: Diving into the GEM Integrative Risk Score
Decoding Risk: Genetic Testing in High-Risk Colon Cancer Patients
GI InsightsDecoding Risk: Genetic Testing in High-Risk Colon Cancer Patients
Diving into the Details of Upadacitinib for UC and Crohn’s Disease
GI InsightsDiving into the Details of Upadacitinib for UC and Crohn’s Disease
Living Well with IBD: Proactive Health Maintenance Strategies
GI InsightsLiving Well with IBD: Proactive Health Maintenance Strategies
The Impact of Anti-Obesity Medications on Digestive Diseases
GI InsightsThe Impact of Anti-Obesity Medications on Digestive Diseases
Passing Screening to Smart Toilets: The Potential of Digital Bowel Movement Biomarkers
GI InsightsPassing Screening to Smart Toilets: The Potential of Digital Bowel Movement Biomarkers
- advertisement
news.ddw.org
06/07/2024
news.ddw.org
06/06/2024
news.ddw.org
06/05/2024